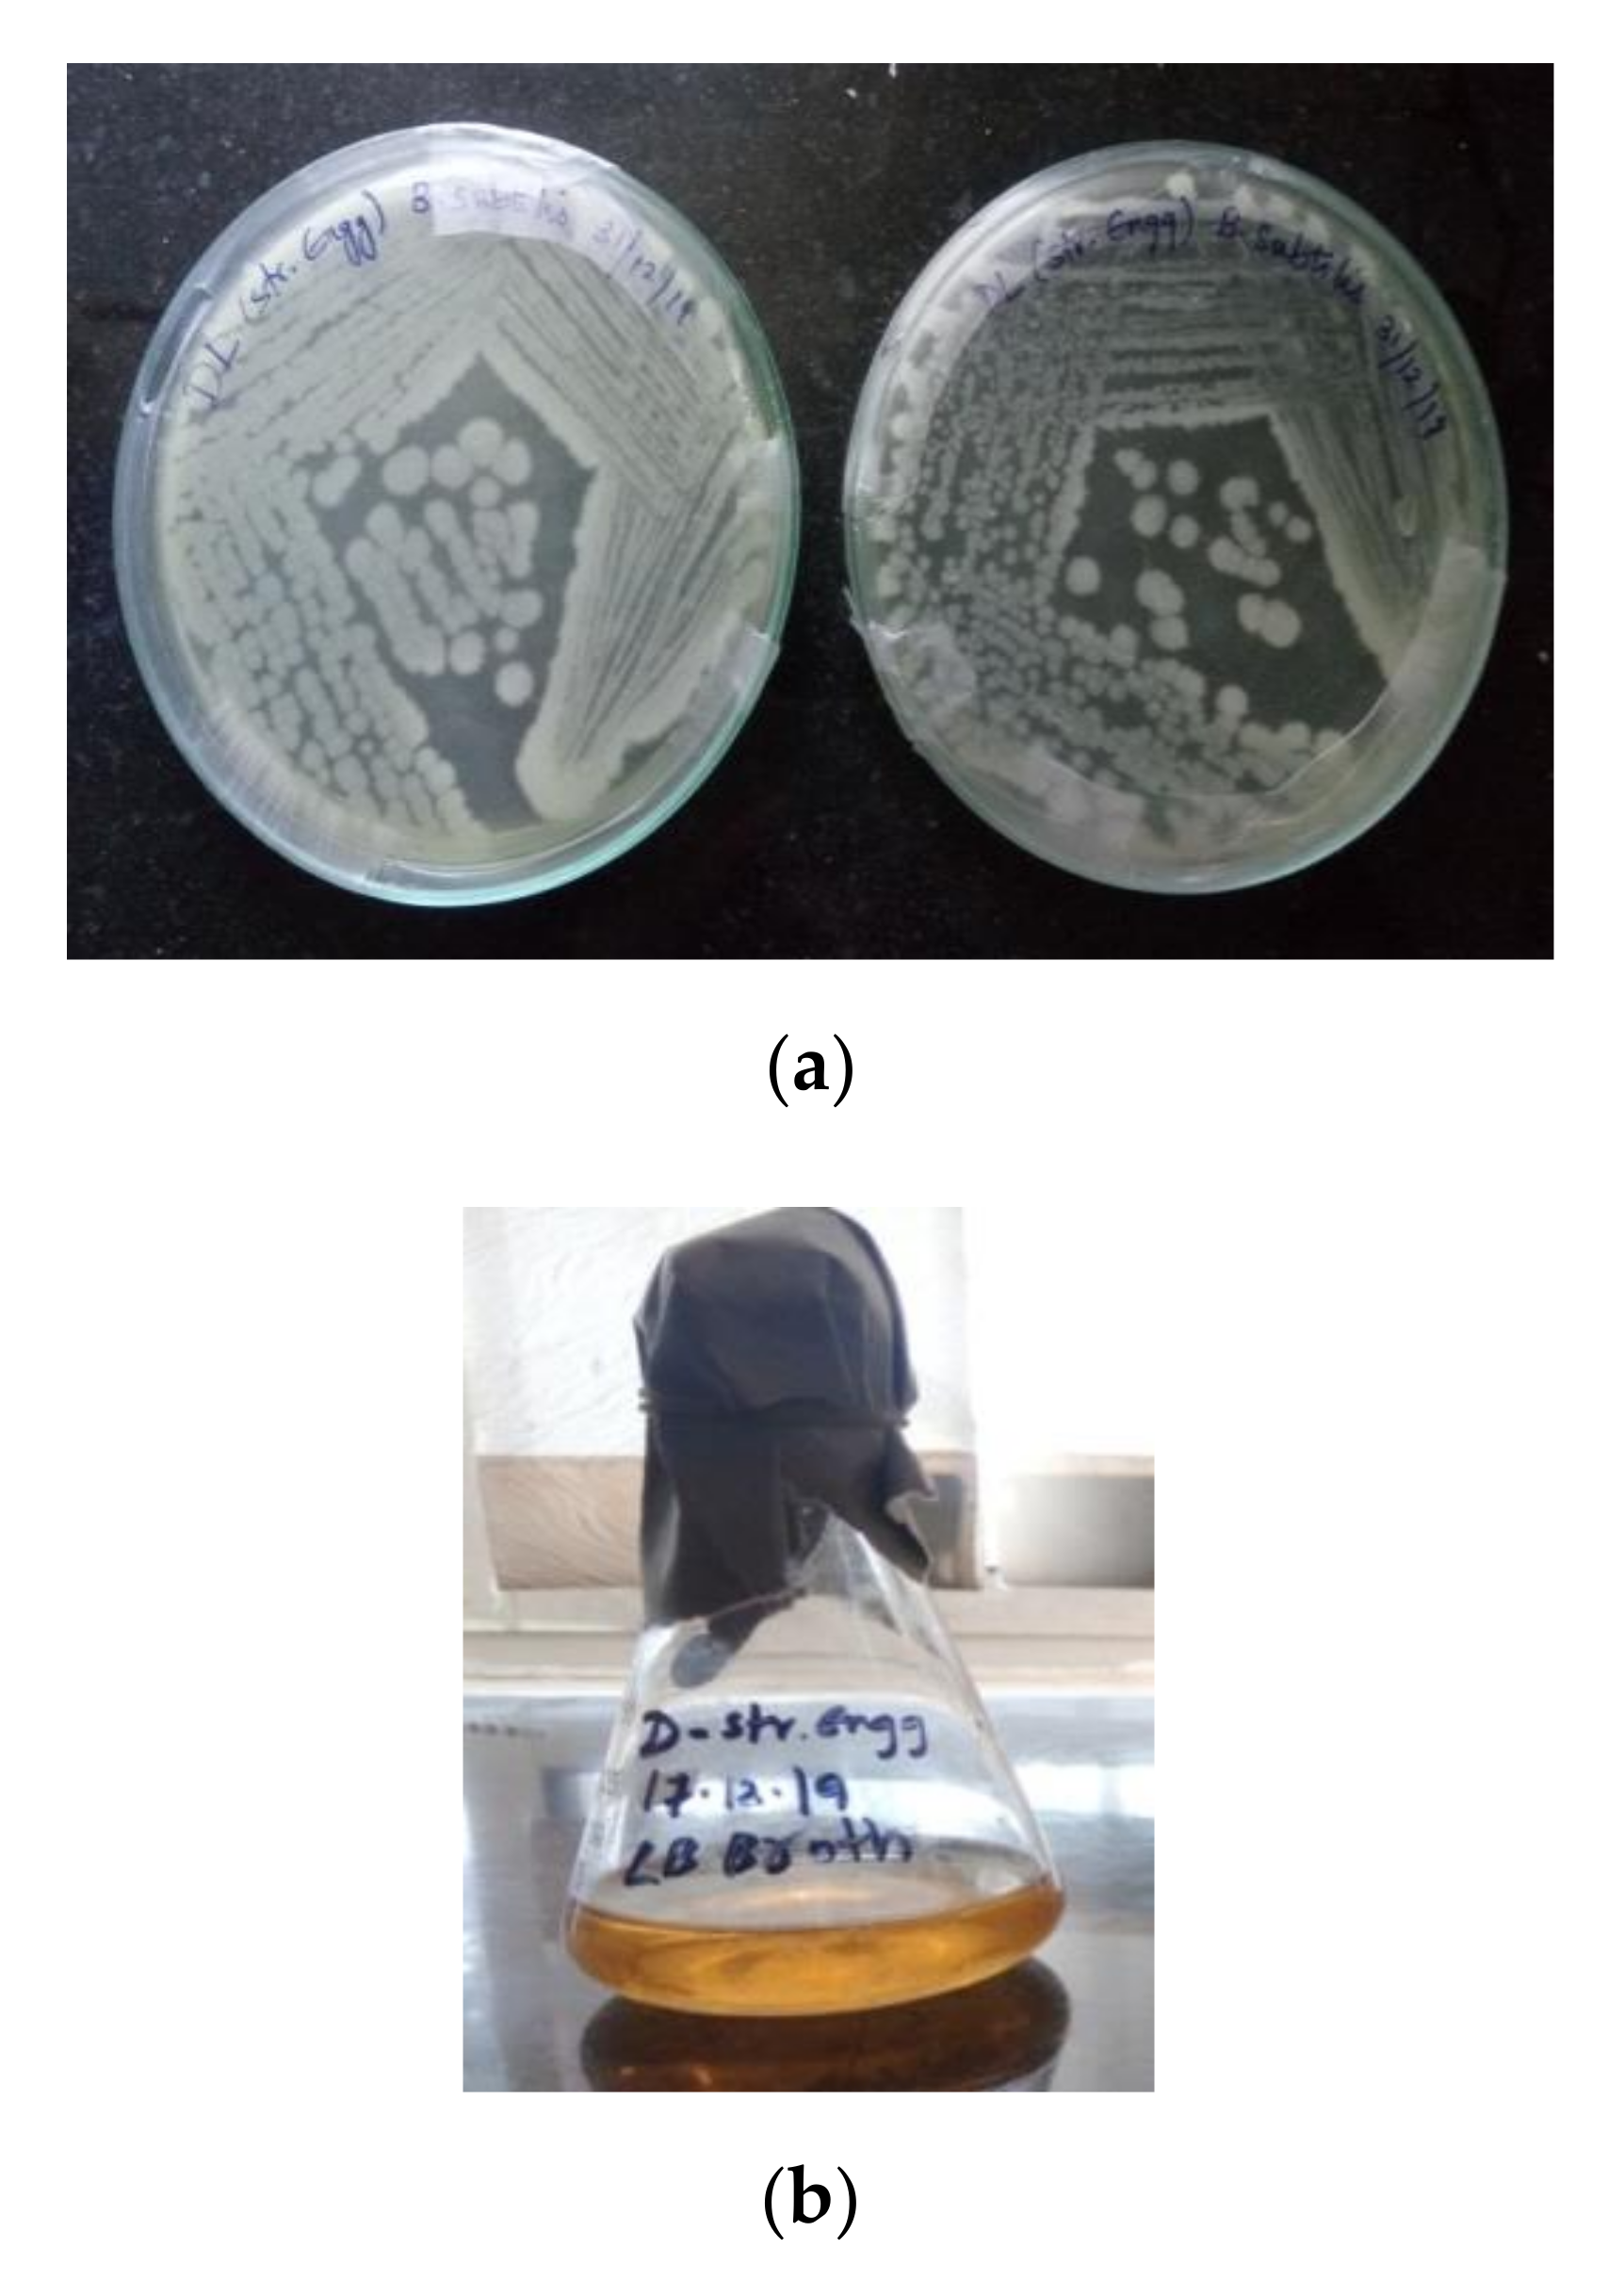
Sustainability 12 10346 g003

Development of Bacterium for Crack Healing and Improving Properties of Concrete under Wet–Dry and Full-Wet Curing
Abstract
:1. Introduction
2. Research Significance
3. Experimental Program
3.1. Preparation of Bacillus Cohnii Bacterial Solution
3.1.1. Isolation of a Bacterial Strain
3.1.2. Identification of Newly Isolated Bacterial Strain by Morphological and Biochemical Characterization
3.1.3. Molecular Characterization of Newly Isolated Bacteria
3.1.4. Preparation of Bacillus cohnii Self-Healing Agent
3.1.5. Results and Interpretation
3.1.6. Bacterial Species: Cultivation
3.1.7. Nutrient or Mineral Substrate
3.1.8. Bacterial Healing Agent Preparation
3.2. Raw Material and Specimen Preparation
3.3. Self-Healing
3.4. Compressive Strength
3.5. Saturated Water Absorption (SWA)
3.6. Sorptivity
3.7. Crack Healing Capacity
3.8. Scanning Electron Microscopy (SEM) and X-ray Diffraction (XRD) Analysis
4. Discussion
4.1. Compressive Strength
4.2. Regained Compressive Strength
4.3. Visual Monitoring of Self-Healing
4.4. Sorptivity
4.5. Water Absorption
4.6. Scanning Electron Microscopy (SEM)
4.7. X-ray Diffraction (XRD)
5. Scope of Future Work
6. Conclusions
Author Contributions
Funding
Acknowledgments
Conflicts of Interest
References
- Kaur, N.P.; Majhi, S.; Dhami, N.K.; Mistri, A. Healing fine cracks in concrete with bacterial cement for an advanced non-destructive monitoring. Constr. Build. Mater. 2020, 242, 118–151. [Google Scholar] [CrossRef]
- Tan, L.; Reeksting, B.; Ferrandiz-Mas, V.; Heath, A.; Gebhard, S.; Paine, K. Effect of carbonation on bacteria-based self-healing of cementitious composites. Constr. Build. Mater. 2020, 257, 119501. [Google Scholar] [CrossRef]
- Chen, H.; Qian, C.; Huang, H. Self-healing cementitious materials based on bacteria and nutrients immobilized respectively. Constr. Build. Mater. 2016, 126, 297–303. [Google Scholar] [CrossRef]
- Souradeep, G.; Dai, P.S.; Wei, K.H. Autonomous healing in concrete by bio-based healing agents—A review. Constr. Build. Mater. 2017, 146, 419–428. [Google Scholar]
- Vijay, K.; Murmu, M.; Deo, S.V. Bacteria based self healing concrete—A review. Constr. Build. Mater. 2017, 152, 1008–1014. [Google Scholar] [CrossRef]
- Zhang, J.L.; Wu, R.S.; Li, Y.M.; Zhong, J.Y.; Deng, X.; Liu, B.; Han, N.X.; Xing, F. Screening of bacteria for self-healing of concrete cracks and optimization of the microbial calcium precipitation process. Appl. Microbiol. Biotechnol. 2016, 100, 6661–6670. [Google Scholar] [CrossRef]
- Chahal, N.; Siddique, R.; Rajor, A. Influence of bacteria on the compressive strength, water absorption and rapid chloride permeability of fly ash concrete. Constr. Build. Mater. 2012, 28, 351–356. [Google Scholar] [CrossRef]
- Siddique, R.; Singh, K.; Kunal; Singh, M.; Corinaldesi, V.; Rajor, A. Properties of bacterial rice husk ash concrete. Constr. Build. Mater. 2016, 121, 112–119. [Google Scholar] [CrossRef]
- Kalhori, H.; Bagherpour, R. Application of carbonate precipitating bacteria for improving properties and repairing cracks of shotcrete. Constr. Build. Mater. 2017, 148, 249–260. [Google Scholar] [CrossRef]
- Siddique, R.; Jameel, A.; Singh, M.; Barnat-Hunek, D.; Kunal; Aït-Mokhtar, A.; Belarbi, R.; Rajor, A. Effect of bacteria on strength, permeation characteristics and micro-structure of silica fume concrete. Constr. Build. Mater. 2017, 142, 92–100. [Google Scholar] [CrossRef]
- Wang, J.; Vandevyvere, B.; Vanhessche, S.; Schoon, J.; Boon, N.; De Belie, N. Microbial carbonate precipitation for the improvement of quality of recycled aggregates. J. Clean. Prod. 2017, 156, 355–366. [Google Scholar] [CrossRef]
- Pan, X.; Shi, Z.; Khayat, K.H.; Ling, T.-C.; Li, N. A review on concrete surface treatment Part I: Types and mechanisms. Constr. Build. Mater. 2017, 132, 578–590. [Google Scholar] [CrossRef]
- Qiu, J.; Tng, D.Q.S.; Yang, E.-H. Surface treatment of recycled concrete aggregates through microbial carbonate precipitation. Constr. Build. Mater. 2014, 57, 144–150. [Google Scholar] [CrossRef]
- Jonkers, H.M.; Thijssen, A.; Muyzer, G.; Copuroglu, O.; Schlangen, E. Application of bacteria as self-healing agent for the development of sustainable concrete. Ecol. Eng. 2010, 36, 230–235. [Google Scholar] [CrossRef]
- De Muynck, W.; Debrouwer, D.; De Belie, N.; Verstraete, W. Bacterial carbonate precipitation improves the durability of cementitious materials. Cem. Concr. Res. 2008, 38, 1005–1014. [Google Scholar] [CrossRef]
- Wang, J.; Van Tittelboom, K.; De Belie, N.; Verstraete, W. Use of silica gel or polyurethane immobilized bacteria for self-healing concrete. Constr. Build. Mater. 2012, 26, 532–540. [Google Scholar] [CrossRef]
- Tziviloglou, E.; Wiktor, V.; Jonkers, H.; Schlangen, E. Bacteria-based self-healing concrete to increase liquid tightness of cracks. Constr. Build. Mater. 2016, 122, 118–125. [Google Scholar] [CrossRef]
- Nosouhian, F.; Mostofinejad, F.; Hasheminejad, H. Influence of biodeposition treatment on concrete durability in a sulfate environment. Biosyst. Eng. 2015, 133, 141–152. [Google Scholar] [CrossRef]
- Nosouhian, F.; Mostofinejad, D. Reducing Permeability of Concrete by Bacterial Mediation on Surface Using Treatment Gel. ACI Mater. J. 2016, 113, 287–293. [Google Scholar] [CrossRef]
- Nosouhian, F.; Mostofinejad, D.; Hasheminejad, H. Concrete Durability Improvement in a Sulfate Environment Using Bacteria. J. Mater. Civ. Eng. 2016, 28, 04015064. [Google Scholar] [CrossRef]
- Balam, N.H.; Mostofinejad, D.; Eftekhar, M. Use of carbonate precipitating bacteria to reduce water absorption of aggregates. Constr. Build. Mater. 2017, 141, 565–577. [Google Scholar] [CrossRef]
- Balam, N.H.; Mostofinejad, D.; Eftekhar, M. Effects of bacterial remediation on compressive strength, water absorption, and chloride permeability of lightweight aggregate concrete. Constr. Build. Mater. 2017, 145, 107–116. [Google Scholar] [CrossRef]
- Tayebani, B.; Mostofinejad, D. Penetrability, Corrosion Potential, and Electrical Resistivity of Bacterial Concrete. J. Mater. Civ. Eng. 2019, 31, 04019002. [Google Scholar] [CrossRef]
- Tayebani, B.; Mostofinejad, D. Self-healing bacterial mortar with improved chloride permeability and electrical resistance. Constr. Build. Mater. 2019, 208, 75–86. [Google Scholar] [CrossRef]
- Parastegari, N.; Mostofinejad, D.; Poursina, D. Use of bacteria to improve electrical resistivity and chloride penetration of air-entrained concrete. Constr. Build. Mater. 2019, 210, 588–595. [Google Scholar] [CrossRef]
- De Muynck, W.; De Belie, D.; Verstraete, W. Improvement of concrete durability with the aid of bacteria. In Proceedings of the 1st International Conference on Self-Healing Materials, Noordwijk aan Zee, The Netherlands, 1 January 2007. [Google Scholar]
- Jafarnia, M.S.; Saryazdi, M.K.; Moshtaghioun, S.M. Use of bacteria for repairing cracks and improving properties of concrete containing limestone powder and natural zeolite. Constr. Build. Mater. 2020, 242, 118059. [Google Scholar] [CrossRef]
- Ghosh, P.; Mandal, S.; Chattopadhyay, B.; Pal, S. Use of microorganism to improve the strength of cement mortar. Cem. Concr. Res. 2005, 35, 1980–1983. [Google Scholar] [CrossRef]
- Bang, S.S.; Galinat, J.K.; Ramakrishnan, V. Calcite precipitation induced by polyurethane-immobilized Bacillus pasteurii. Enzym. Microb. Technol. 2001, 28, 404–409. [Google Scholar] [CrossRef]
- Van Tittelboom, K.; De Belie, N.; De Muynck, W.; Verstraete, W. Use of bacteria to repair cracks in concrete. Cem. Concr. Res. 2010, 40, 157–166. [Google Scholar] [CrossRef]
- Wiktor, V.; Jonkers, H.M. Quantification of crack-healing in novel bacteria-based self-healing concrete. Cem. Concr. Compos. 2011, 33, 763–770. [Google Scholar] [CrossRef]
- Gollapudi, U.; Knutson, C.; Bang, S.; Islam, M. A new method for controlling leaching through permeable channels. Chemosphere 1995, 30, 695–705. [Google Scholar] [CrossRef]
- Nemati, M. Modification of porous media permeability, using calcium carbonate produced enzymatically in situ. Enzym. Microb. Technol. 2003, 33, 635–642. [Google Scholar] [CrossRef]
- Stocks-Fischer, S.; Galinat, J.K.; Bang, S.S. Microbiological precipitation of CaCO3. Soil Biol. Biochem. 1999, 31, 1563–1571. [Google Scholar] [CrossRef]
- DeJong, J.T.; Mortensen, B.M.; Martinez, B.C.; Nelson, D.C. Bio-mediated soil improvement. Ecol. Eng. 2010, 36, 197–210. [Google Scholar] [CrossRef]
- Mondal, S.; Das, P.; Chakraborty, A.K. Application of Bacteria in Concrete. Mater. Today Proc. 2017, 4, 9833–9836. [Google Scholar] [CrossRef]
- Abudoleh, S.M.; Al Mahayreh, A.; Al Frejat, A.; Al Hulaisy, F.; Hamdan, S.O. Bioconcrete Development Using Calcite-Precipitating Bacteria Isolated from Different Sources. In Proceedings of the 2nd International Conference on Building Materials and Materials Engineering, MATEC Web of Conferences, Lisbon, Portugal, 26–28 September 2018; Available online: https://www.matec-conferences.org/articles/matecconf/abs/2019/27/matecconf_icbmm2018_01011/matecconf_icbmm2018_01011.html (accessed on 30 October 2020).
- Chahal, N.; Rajor, R.; Siddique, A. Calcium carbonate precipitation by different bacterial strains. Afr. J. Biotechnol. 2011, 10, 8359–8372. [Google Scholar]
- Jagadeesha Kumar, B.G.; Prabhakar, R.; Pushpa, H. Bio mineralization of calcium carbonate by different bacterial strains and their application in concrete crack remediation. Int. J. Adv. Eng. Technol. 2013, 6, 202–213. [Google Scholar]
- Zhang, J.; Liu, Y.; Feng, T.; Zhou, M.; Zhao, L.; Zhou, A.; Li, Z. Immobilizing bacteria in expanded perlite for the crack self-healing in concrete. Constr. Build. Mater. 2017, 148, 610–617. [Google Scholar] [CrossRef]
- Zhang, J.; Zhou, A.; Liu, Y.; Zhou, B.; Luan, Y.; Wang, S.; Yue, X.; Li, Z. Microbial network of the carbonate precipitation process induced by microbial consortia and the potrntial application to crack healing in concrete. Sci. Rep. 2017, 7, 14600. [Google Scholar] [CrossRef]
- Tamura, K.; Dudley, J.; Nei, M.; Kumar, S. MEGA4: Molecular Evolutionary Genetics Analysis (MEGA) Software Version 4.0. Mol. Biol. Evol. 2007, 24, 1596–1599. [Google Scholar] [CrossRef]
- Kim, O.-S.; Cho, Y.-J.; Lee, K.; Yoon, S.-H.; Kim, M.; Na, H.; Park, S.-C.; Jeon, Y.S.; Lee, J.-H.; Yi, H.; et al. Introducing EzTaxon-e: A prokaryotic 16S rRNA gene sequence database with phylotypes that represent uncultured species. Int. J. Syst. Evol. Microbiol. 2012, 62, 716–721. [Google Scholar] [CrossRef]
- IS. Specification for 53 Grade Ordinary Portland Cement; Bureau of Infdian Standard: New Delhi, India, 2013. [Google Scholar]
- IS. Coarse and Fine Aggregate for Concrete—Specification; Bureau of Infdian Standard: New Delhi, India, 2016. [Google Scholar]
- IS. Method of Tests for Strength of Concrete; Bureau of Indian Standards: New Delhi, India, 2004. [Google Scholar]
- ASTM. Standard Test. Method for Density, Absorption, and Voids in Hardened Concrete; ASTM International: West Conshohocken, PA, USA, 2013. [Google Scholar]
- ASTM. Standard Test. Method for Measurement of Rate of Absorption of Water by Hydraulic-Cement Concretes; ASTM International: West Conshohocken, PA, USA, 2020. [Google Scholar]
- Achal, V.; Pan, X.; Özyurt, N. Improved strength and durability of fly ash-amended concrete by microbial calcite precipitation. Ecol. Eng. 2011, 37, 554–559. [Google Scholar] [CrossRef]
- Khaliq, W.; Ehsan, M.B. Crack healing in concrete using various bio influenced self-healing techniques. Constr. Build. Mater. 2016, 102, 349–357. [Google Scholar] [CrossRef]
- Priya, T.S.; Ramesh, N.; Agarwal, A.; Bhusnur, S.; Chaudhary, K. Strength and durability characteristics of concrete made by micronized biomass silica and Bacteria-Bacillus sphaericus. Constr. Build. Mater. 2019, 226, 827–838. [Google Scholar] [CrossRef]
- Krishnapriya, S.; Babu, D.L.V.; G., P.A. Isolation and identification of bacteria to improve the strength of concrete. Microbiol. Res. 2015, 174, 48–55. [Google Scholar] [CrossRef]
- Nain, N.; Surabhi, R.; Yathish, N.; Krishnamurthy, V.; Deepa, T.; Tharannum, S. Enhancement in strength parameters of concrete by application of Bacillus bacteria. Constr. Build. Mater. 2019, 202, 904–908. [Google Scholar] [CrossRef]

| S. No | Test | Observation |
|---|---|---|
| 1. | Configuration | Circular |
| 2. | Surface | Smooth |
| 3. | Pigment | White |
| 4. | Opacity | Opaque |
| 5. | Gram’s reaction | Gram positive |
| 6. | Cell shape | Rods |
| 7. | Arrangement | Chains |
| 8. | Spore(s) | + |
| 9. | Motility | + |
| 10. | Indole | + |
| 11. | Methyl Red | - |
| 12. | Voges–Proskauer | + |
| 13. | Citrate | + |
| 14. | Triple sugar iron | + |
| 15. | Catalase | + |
| 16. | Starch hydrolysis | + |
| 17. | Casein hydrolysis | + |
| 18. | Urease | + |
| 19. | Gelatinase | + |
| Mix Id | Cement (kg/m3) | FA (kg/m3) | CA (kg/m3) | Water (kg/m3) | Bacterial Cell Solution (%) | Nutrient Solution (%) | Curing Method |
|---|---|---|---|---|---|---|---|
| RS | 438 | 710 | 1110 | 219 | 0 | 0 | Full-wet |
| W-D | 438 | 710 | 1110 | 219 | 5 | 95 | Wet–dry cycles |
| F-W | 438 | 710 | 1110 | 219 | 5 | 95 | Full-wet |
| Mix Id | Initial Crack Width (mm) | Crack Healed Size (mm) | Crack Healing (%) | ||||
|---|---|---|---|---|---|---|---|
| 3 Days | 7 Days | 28 Days | 3 Days | 7 Days | 28 Days | ||
| RS | 0.42 | 0.42 | 0.42 | 0.42 | 0 | 0 | 0 |
| W-D | 0.38 | 0.305 | 0.224 | 0.045 | 20 | 41 | 88 |
| F-W | 0.37 | 0.285 | 0.201 | 0.037 | 23 | 46 | 90 |
Publisher’s Note: MDPI stays neutral with regard to jurisdictional claims in published maps and institutional affiliations. |
© 2020 by the authors. Licensee MDPI, Basel, Switzerland. This article is an open access article distributed under the terms and conditions of the Creative Commons Attribution (CC BY) license (http://creativecommons.org/licenses/by/4.0/).
Share and Cite
Sumathi, A.; Murali, G.; Gowdhaman, D.; Amran, M.; Fediuk, R.; Vatin, N.I.; Deeba Laxme, R.; Gowsika, T.S. Development of Bacterium for Crack Healing and Improving Properties of Concrete under Wet–Dry and Full-Wet Curing. Sustainability 2020, 12, 10346. https://doi.org/10.3390/su122410346
Sumathi A, Murali G, Gowdhaman D, Amran M, Fediuk R, Vatin NI, Deeba Laxme R, Gowsika TS. Development of Bacterium for Crack Healing and Improving Properties of Concrete under Wet–Dry and Full-Wet Curing. Sustainability. 2020; 12(24):10346. https://doi.org/10.3390/su122410346
Chicago/Turabian StyleSumathi, Arunachalam, Gunasekaran Murali, Dharmalingam Gowdhaman, Mugahed Amran, Roman Fediuk, Nikolai Ivanovich Vatin, Ramamurthy Deeba Laxme, and Thillai Seenu Gowsika. 2020. "Development of Bacterium for Crack Healing and Improving Properties of Concrete under Wet–Dry and Full-Wet Curing" Sustainability 12, no. 24: 10346. https://doi.org/10.3390/su122410346
APA StyleSumathi, A., Murali, G., Gowdhaman, D., Amran, M., Fediuk, R., Vatin, N. I., Deeba Laxme, R., & Gowsika, T. S. (2020). Development of Bacterium for Crack Healing and Improving Properties of Concrete under Wet–Dry and Full-Wet Curing. Sustainability, 12(24), 10346. https://doi.org/10.3390/su122410346

